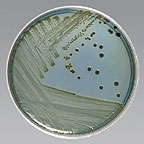

Details
- Manufacturer: Hardy
- Mfr. Cat. # G63
- Brand Name: Hardy
Microbiology » Culture Media Plates
HE (Hektoen Enteric) Agar (Hardy)
Medix Item Code: HHE-0063
$16.00 per Pack
List Price: $18.29
You Save: $2.29 (13%)
Size: 10/pk.
Special shipping requirements
- Refrigerated - This item is refrigerated and must ship by air with ice.
Features
- For the selective isolation of pathogenic gram negative enteric bacteria, such as Salmonella spp.
Description
HE (Hektoen Enteric) Agar for the selective isolation of pathogenic gram negative enteric bacteria, such as Salmonella spp. and Shigella spp.
Similar items
These items may also interest you:
About Medix
Want to learn more about us? MedixCorp.com strives to put the customer first. Read here to find out how we can serve you!
Placing an Order
Placing an order with Medix is easy! Shop on-line, or order by fax, e-mail, or telephone.
Contact Us
Need to get a hold of us? Medix offers many convenient ways to get in touch with our customer service team.
Monthly Specials
Want to save on many of our most popular items? Medix offers money saving new specials every month!
Quick Order
Common units include:
cs (case), pk (pack) and ea (each).